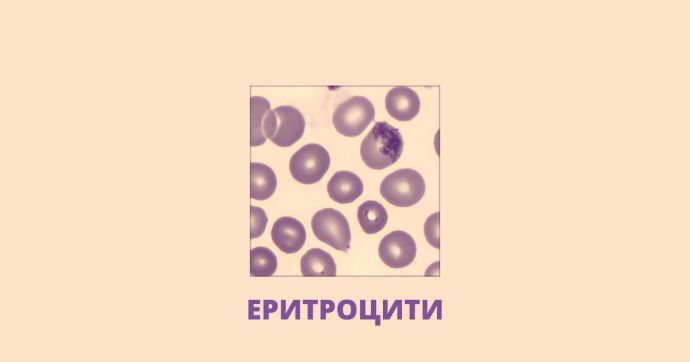

За първи път с просто око можем да надникнем в пълна кръвна картина. Как става това? Отговорът е чрез високите технологии, които се използват в новата централна лаборатория на „ЛИНА”. Тя е единствената в страната, която разполага с автоматизирана хематологична система Sysmex XN-9100. Модерната апаратура показва детайлно различните групи клетки в кръвната картина, която е в основата на диагностиката на редица заболявания.
Важно е да се знае, че Sysmex XN-9100 помага за още по-високо качество на резултатите. На монитор той визуализира изображение на кръвната натривка, която лабораторните лекари обикновено наблюдават под микроскоп. За тази цел апаратът първо определя показателите на кръвната картина, след което сам прави натривката, оцветява я и чрез дигитален микроскоп извършва диференциално броене. След това лекарят проверява дали клетките, които са изброени, са правилно диференцирани.
Лекарите контролират целия процес и при необходимост могат да преместят дадена клетка в друг клас, ако преценят, че апаратът не я е определил правилно, като по този начин крайният резултат задължително се прецизира и валидира от тях. Специалистът по клинична лаборатория д-р Пламена Хараланова разкрива повече за модерното оборудване.
-Д-р Хараланова, с какво този апарат прави диагностиката по-точна?
-Резултатите от такъв високотехнологичен апарат са по-прецизни, защото се елиминират възможностите за грешки, които могат да се допуснат при направата на кръвните натривки и тяхното оцветяване. Тук тези процеси са автоматизирани и стандартизирани, като изображенията на клетките, които виждаме на монитора на апарата, се доближават до тези в атласите по хематология, от които сме се учили. Такова качество на кръвната натривка трудно би могло да се постигне при ръчната им направа. Също така софтуерът на апарата позволява дадена клетка да бъде допълнително увеличена, за да можем да разгледаме в детайли структурата й и да забележим и дискретни промени, ако има такива. Апаратът е настроен така, че по зададени критерии да прави кръвна натривка дори и на пациентски проби, които нямат назначена диференциална кръвна картина. Това заостря нашето внимание върху такива патологични проби и по този начин могат да се диагностицират кръвни заболявания в по-ранен етап.
-Какви са различните видове клетки?
-Нека заедно да погледнем под микроскопа на този модерен апарат и да видим какви клетки можем да наблюдаваме. Първо, веднага ще видим еритроцитите – най-многобройните клетки в кръвта, тези които съдържат хемоглобин, придават червения й цвят и които пренасят жизнено важния за организма кислород до всяка негова клетка.
Разглеждайки ги, можем да установим дали те са достатъчно снабдени с желязо или изглеждат по-бледи, с по-голямо централно просветляване, което е белег за анемия. Можем да наблюдаваме различни изменения в тяхната големина, форма, оцветка, да откриваме патологични включвания в тях и така да диагностицираме различни болестни състояния.
Между еритроцитите можем да забележим и едни по-малки клетки, подобни на червени точици, които обаче са много важни, защото участват в съсирването на кръвта и така я поддържат в течно състояние – това са тромбоцитите.
Понякога, в резултат на заболявания, те намаляват до степен, че почти не ги откриваме на една такава кръвна натривка. Това е опасно и може да доведе до кръвоизливи на различни места в организма.
-Кои са клетките-стражи, които се борят с вирусите и бактериите?
-Белите кръвни клетки или левкоцитите са тези защитници на организма. Те ни предпазват от инфекции и се увеличават, когато организмът се опитва сам да се справи с даден патоген. Наричат се така, защото не съдържат хемоглобин. Делят се на няколко групи, всяка от които изпълнява определена функция.
Неутрофилните гранулоцити – тяхната функция е да неутрализират бактериалните причинители на инфекциите.
При тежки заболявания, можем да наблюдаваме тези клетки в различна степен на зрялост. Появяват се гранулоцити в по-ранен стадий на съзряване, което означава, че костният мозък е активиран и ги произвежда по-бързо, тъй като организмът има повишена нужда от тях в този момент и те не успяват да узреят, а постъпват в периферната кръв по-рано, с цел да упражнят своята защитна функция.
А това са еозинофилните гранулоцити – най-красивите клетки в кръвта със своите големи оранжеви гранули.
Това са клетките, които ни защитават от паразитите и участват в отговора към алергични реакции.
Базофилите са най-рядко срещаните клетки в кръвта. Те освобождават хистамин и също участват в алергичните реакции.
Лимфоцитите са клетките, които реагират при среща с вирусни причинители, а също така осигуряват и имунната памет на организма за срещата с тези причинители.
Те могат да претърпят различни промени в морфологията си при хематологични и инфекциозни заболявания, които ние може да наблюдаваме под микроскопа.
Моноцитите са клетките, които също се озовават на инфектираното място в организма, но по-бавно от неутрофилите, като тяхната функция е да отстранят умиращите клетки, затова те се повишават във възстановителната фаза на една инфекция.
-Защо пълната кръвна картина (ПКК) е толкова важна и почти винаги, когато отидем на лекар, ни я назначават?
-С изследването на ПКК може да се диагностицират състояния като анемия, да се определи с голяма точност какъв вид е тя, да се установи наличие на инфеция или по-сериозно кръвно заболяване. Изследването на ПКК е в полза при диагностиката на почти всички заболявания и е неотменна част от задължителните изследвания за проследяване на здравословния статус на организма.